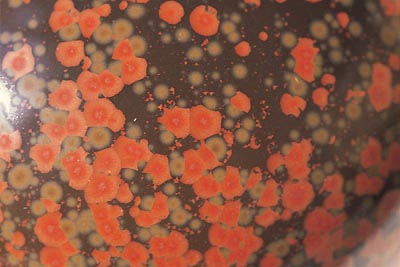
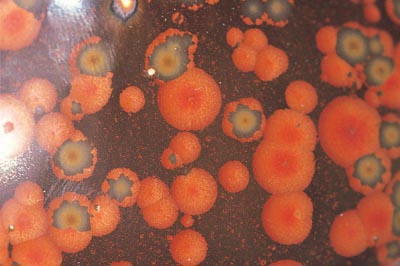

·ç »þ¿ÀÃß¾Ó(åûüûíä)°ú öȫ±Ý±ÇÀ¯(ôÑûõÐÝÏêë¸)
±Û/ ¿ì°üÈ£ (È«ÀÍ´ëÇб³ºÎ¼³ µµ¿¹¿¬±¸¼¾ÅÍ ¼ÒÀå)
ÜýóÝÜþâË.
·ç »þ¿ÀÃß¾ÓÀº Áö³ ´Þ¿¡ ¼Ò°³ÇÏ¿´´ø ¯ ¼î¿ìÂê±³¼öÀÇ ºÎÀÎÀÌÀÚ Ã¶À¯(ôÑë¸) ¿¬±¸°¡·Î¼ ÇöÀç ĪȴëÇÐ ±³¼ö·Î ÀçÁ÷ ÁßÀÌ´Ù.
±¤Àú¿ì(ÎÆñ¶) ȳ(ü¤Ñõ)À̰ø´ëÇРȰø°ú ¹× ±Ô»ê¿° Àü¹®´ëÇÐ º»°ú¸¦ Á¹¾÷ÇÏ¿´°í Áß±¹µµÀÚ°ø¾÷Çùȸ Àå½ÄÀç·á Àü¹®À§¿øÈ¸ÀÇ À§¿øÀ» °âÇϰí ÀÖ´Ù.
´ëÇп¡¼´Â µµÀÚ°ø¿¹Çаú µµÀÚÀç·á°ø¿¹½ÇÇè µîÀÇ ±³°ú¸ñÀ» ´ã´çÇϰí ÀÖÀ¸¹Ç·Î ¾ö¹ÐÇÑ Àǹ̿¡¼ º¸¸é ÀÛ°¡¶ó±â º¸´Ù´Â Àç·áÇÐÀÚ¶ó´Â Ç¥ÇöÀÌ ¾î¿ï¸± ¼öµµ ÀÖ´Ù.
µû¶ó¼ À̹ø¿¡ ¼Ò°³ÇÒ ³»¿ëµµ ·ç »þ¿ÀÃß¾ÓÀÌ ¿À·£ ±â°£ µ¿¾È ¿¬±¸ÇØ ¿Â öÀ¯(ôÑë¸)°¡ Áß½ÉÀÌ µÈ´Ù. ±×·¯³ª À¯¾à¿¡ ±¹ÇÑÇÏÁö ¾Ê°í ±×°Í¿¡ ´ëÇÑ ÇÑ »ç¶÷ÀÇ »ý°¢°ú ³ë·ÂÀ» ¼Ò°³ÇϰíÀÚ ÇÑ´Ù.

ù°, Àü¹®¼º
±×ÀÇ ³ªÀÌ ¿ÃÇØ 69¼¼´Ï±î ²Ï ¿À·¡Àü ºÎÅÍ ÇϳªÀÇ ¸ñÇ¥¿¡ ¸ÅÁøÇØ ¿Â ¼ÀÀÌ´Ù. ¿ì¸®³ª¶ó¿¡µµ ¿À·£ ±â°£ ¹éÀÚÀÇ »ö¸¸ ¿¬±¸ÇØ ¿Â ÀÛ°¡°¡ ÀÖ´Ù. ¹éÀÚÀÇ Èë°ú À¯¾à¿¡¸¸ ÁýÂøÇÏ¿© µ¶º¸ÀûÀÎ Àϰ¡¸¦ ÀÌ·ç¾ú´Ù°í Æò°¡µÇ´Â ±× ÀÛ°¡Ã³·³ ·ç »þ¿ÀÃß¾Ó ¿ª½Ã 40³âÀ» Èǽ ³Ñ±ä ¼¼¿ùµ¿¾È ÀڽŸ¸ÀÇ ¿¬±¸¿¡ ÃµÂøÇØ ¿Â ¼ÀÀÌ´Ù.
Á¶Çü¿¹¼úǰÀÇ Á¶°ÇÀÌ Çü°ú »öä, Áú°¨ÀÇ ¼¼¿ä¼Ò°¡ ÀûÀýÈ÷ ¾î¿ì·¯Á®¾ß ÇÑ´Ù´Â °ÍÀº ÁÖÁöÀÇ »ç½ÇÀÌ´Ù. ƯÈ÷ µµ¿¹ÀÇ °æ¿ì´Â ±× Á¶°ÇÀ» ÃæÁ·½ÃŰ´Â °ÍÀÌ ¹«¾ùº¸´Ù °íµÇ°í Áö³ÇÏ´Ù. ¼¼»ó¿¡ Á¸ÀçÇÏ´Â ¸¹Àº Àç·áµéÀº °æ¿ì¿¡ µû¶ó ±× ¼ººÐÀÌ ´Ù¸£°í ¼Ò¼ºÈ¯°æ¿¡ µû¶ó ±Þº¯ÇÏ´Â °æ¿ìµµ ¸¹´Ù. ´õ¿íÀÌ ÀÚ½ÅÀÇ ÁÖ¿ä ¿¬±¸°úÁ¦°¡ Çϳª·Î ±¹ÇѵǾîÀÖ°í ±× °á°úÄ¡°¡ ½±°Ô µµÃâµÇÁö ¾Ê´Â °æ¿ì¿¡´Â °á±¹ ÀڽŰúÀÇ ½Î¿òÀ¸·Î Ä¡´Ý´Â °æ¿ì°¡ ¸¹´Ù.
¹Ù·Î ÀÌ Á¡ÀÌ Àü¹®¼ºÀ̶ó°í ¸»ÇÏ°í ½ÍÀ¸¸ç ·ç »þ¿ÀÃß¾Ó ¿ª½Ã ±×·¯ÇÑ ¹üÁÖ¿¡ ¼ÓÇÏ´Â ±Í°¨ÀÌ µÇ´Â °ÍÀÌ´Ù.
µÑ°, ¿ª»ç¼º
·ç »þ¿ÀÃß¾ÓÀÌ ¸ÅÁøÇϰí ÀÖ´Â ºÎºÐÀº ±ÛÀÇ ¼µÎ¿¡¼µµ ¹àÈù öÀ¯ °è¿ÀÌ´Ù. ±×°¡ ¸¸µç öȫ±Ý±ÇÀ¯(ôÑûõÐÝÏêë¸)´Â ¸» ±×´ë·Î öÀ» ÁÖ¼ººÐÀ¸·Î ÇÏ´Â À¯¾àÀ¸·Î¼ £Àº °¥»öÀÇ ¹ÙÅÁÀ§¿¡ Àû»ö ¹ÝÁ¡ÀÌ ÇÇ¸ç ¹ÝÁ¡ ÁÖÀ§¿¡´Â ±Ý»ö Å׵θ®°¡ µÑ·¯Á® ÀÖ´Ù. ¾óÇͺ¸¸é °áÁ¤À¯°°À¸³ª °áÁ¤À¯´Â ¾Æ´Ï¸ç ÇöÀç ÀϺ»ÀÇ ±¹º¸·Î ÁöÁ¤µÇ¾î ÀÖ´Â ¼ÛÀÇ ¾ß¿ÀºóޏðÄí(é¢Ü¨ô¸ÙÍ)1)(±×¸²1)¿Í °°Àº °è¿À̶ó°í ÇÒ ¼ö ÀÖ´Ù.
·ç »þ¿ÀÃß¾ÓÀº ÀÚ½ÅÀÇ À¯¾àÀ» À§ÇØ ¿ª»çÀû »ç½Ç¿¡ ´ëÇÑ ¿¬±¸¸¦ ¼±ÇàÇÏ¿´´Ù. ÁÖÁöÇÏ´Ù½ÃÇÇ Áß±¹Àº Àڱ⸦ ¹ß¸íÇÑ ³ª¶óÀÌ´Ù. ¶¥ÀÌ ³Ð°í Àα¸°¡ ¸¹Àº ´öºÐ¿¡ ´ÙÁ¾´Ù¾çÇÑ Àç·á¸¦ °³¹ßÇß°í ¸¹Àº µµ°øµéÀÇ ºÎ´ÜÇÑ ½ÇÇè¿¡ ÀÇÇØ ¹éÀÚ¿Í Ã»ÀÚ¸¦ ¹ß¸íÇßÀ¸¸ç ±×°ÍÀº ¿À´Ã³¯ µµÀÚ¹®È¸¦ ²ÉÇÇ¿ì°ÔÇÏ´Â ¿øµ¿·ÂÀÌ µÇ¾ú´Ù. ƯÈ÷ Áö±¸»óÀÇ ±¤¹° Áß¿¡ °¡Àå ¸¹ÀÌ ÇÔÀ¯µÇ¾î Àִ öÀ» ÀÌ¿ëÇÏ¿© ûÀÚÀ¯¿Í ÈæÀ¯, õ¸ñÀ¯ µîÀ» ¸¸µç ¿À·£ ¿ª»ç¸¦ °¡Áö°í ÀÖ´Ù. ƯÈ÷ öÀÇ ÇÔ·®°ú ¼ººÐ, ³óµµºÐÆ÷ ¹× ¹°¸®Àû »óÅÂÀÇ Â÷ÀÌ µîÀº À¯¾àÀÇ »ö, Áú°¨, ¿¹¼úÀû Á¶Çü¼º¿¡ °áÁ¤Àû ¿µÇâÀ» ¹ÌÃÆ´Ù.

±×¸²1 áäÓÛÐ·é¢ Î¸°ú Úï
"Áß±¹¹Î¿¡°Ô ¿Á±â(è¬Ðï)´Â »ó¼(ßÔßú)¿Í ¹ÌÀÇ »ó¡À̸ç ûÀÚ´Â ¼öÁ¤°ú ºñÃëÀÇ »ö°ú Áú°¨À» Ãß±¸ÇÑ °ÍÀ¸·Î¼ ¸¼°í ±ú²ýÇÏ¸ç ¿Ïº®ÇÑ ¿Á°ú °°´Ù. À̿Ͱ°Àº Áß±¹¹ÎÀÇ Á¤¼¿¡ ºÎÀÀÇÑ ¿ì¼öÇÑ µµÀÚ±âµéÀÌ ¼Û´ë¿¡ À̸£·¯ ÀýÁ¤À» º¸°Ô µÇ¾úÀ¸¸ç ±× ±ÙÀú¿¡´Â ´Ù¾çÇÑ À¯¾àÀÇ ¿Ï¼ºÀÌ ÀÖ¾ú´Ù. ¼Û´ëÀÇ 5´ë ¸í¿äÀÎ " ÁÖ(æ£), Ää(ί), ²¨(ʨ), ¶ò(ïÒ), Ãá(з)" Áß ¶ò¿ä¸¦ Á¦¿ÜÇÑ ³ª¸ÓÁö ³× °÷Àº ¸ðµÎ ûÀÚ¸¦ »ý»êÇÏ¿´´Ù. ¶ÇÇÑ ·ÕÃß¾Ø(éÌô»)¿ä, ¾ß¿ÀÂÉ¿ì(é¥ñ¶)¿ä, ¡´õÀü(ÌØÓìòå)ÀÇ ÈÄÆ¼¿Â(ûÉï£)¿ä µî¿¡¼µµ ûÀÚ°¡ ¸¸µé¾îÁ³´Ù.
¶ÇÇÑ ÀÌ °¡¸¶µéÀº À¯¾àÀÇ ¹Ì¸¦ Ãß±¸ÇÏ¿´´Ù. ¾è°Ô ºñÄ¡´Â Åõ¸íÇÑ ÆÄ¸®À¯(÷ç×ãë¸)2)´Â ¹°·Ð, ÀçÁúÀÇ ¾Æ¸§´Ù¿òÀ» µ¸º¸ÀÌ°Ô ÇÏ´Â À¯Å¹À¯(êáöúë¸)´Â À¯¸éÀÇ ¹Ì¼¼ÇÑ ±âÆ÷·Î ÀÎÇÑ ºûÀÇ ±¼Àý, »ê¶õÀ» Çü¼ºÇÏ¿© Â÷ºÐÇÑ ¾Æ¸§´Ù¿òÀ» º¸¿©ÁÜÀ¸·Î½á µµ ÀÚ¹ÌÇÐÀÇ °íÂ÷¿øÀû °æÁö¸¦ ÀÌ·ç¾ú´Ù.
¼ÛÀÇ °ü¿äµéÀº ûÀÚÀÇ ³»ÀçÀû ǰÁúµéÀ» ½ÉȽÃÄ×°í ÁÖ(æ£)¿äÀÇ °Í ÀÌ·¡·Î ûÀÚ¹®¾çÀÇ °³¹ß¿¡ ÈûÀ» ±â¿ï¿© ÃÖ»óÀÇ °æÁö¿¡ µµ´ÞÇÏ¿© Áß±¹ ûÀÚÀÇ ¹ÌÀû ±Ô¹üÀÌ µÇ¾ú´Ù. ¼Û´ë¿¡´Â ûÀÚ¸¦ Á¦¿ÜÇÑ ÈæÀ¯µµÀÚµµ ¿ì¼öÇÑ ¼öÁØ¿¡ À̸£·¶À¸¸ç Áö¾Ø(Ëï)¿äÀÇ ¿ä¿ì¶ì(êúîÙ)À¯3), ÅõÇÏ¿À(÷ÍûÆ)À¯4), ÁöÂÉ¿ì(ÑÎñ¶)¿äÀÇ µûÀ̸¶¿À(ÓåÙÁ)À¯5), »ê¾¾(ߣà¤)ÀÇ È«¿ä¿ì¶ì(ûõë¸îÙ)6) µîÀº ¿õÈ¥ÇÏ¸ç ¿ì¾ÆÇÏ°í ´ë¹üÇÑ ¸ÀÀ¸·Î ¿¹¼úÀû ¸Å·ÂÀÌ ³ÑÄ£´Ù. ÀÌ¿Í °°Àº ¼Û´ëÀÇ ÈæÀ¯µéÀº ±× ¹üÀ§°¡ ¸Å¿ì ³Ð°í À¯¾àÀÇ Âø»öÁ¦·Î¼ öÀÌ ³Î¸® ÀÀ¿ëµÈ »ç½ÇÀ» ÀÔÁõÇÏ´Â °ÍÀÌ´Ù. "
Áö¸é»ó Àü¹®À» ¼Ò°³ÇÒ ¼ø ¾øÁö¸¸ À§ÀÇ ÂªÀº ±Û¸¸ º¸´õ¶óµµ ·ç »þ¿ÀÃß¾ÓÀº ¿ª»çÀû »ç½Ç¿¡ ´ëÇÑ ¿¬±¸ÀÇ ¹ÙÅÁÀ§¿¡ ÀڽŸ¸ÀÇ À¯¾à âÁ¶¿¡ ³ë·ÂÀ» ±â¿ï¿´À½À» ¾Ë ¼ö ÀÖ´Ù.
¼Â°, °úÇÐÀû ޱ¸¼º
ÇÊÀÚÀÇ ÂªÀº Áß±¹¾î ½Ç·Â Å¿µµ ÀÖÁö¸¸ ÀÌ ±ÛÀ» À§ÇØ ·ç »þ¿ÀÃß¾ÓÀÌ º¸³½ Âü°íÀÚ·á´Â ÈÇи®Æ÷Æ®¸¦ º¸´Â ´À³¦À̾ú´Ù.
±×´Â öȫ±Ý±ÇÀ¯(ôÑûõÐÝÏêë¸)¸¦ ÀüÅëÀû öÀ¯ÀÇ ¾×»óºÐÃþÇö»ó(äûßÓÝÂöµúÞßÚ)À» °è½Â ¹ßÀü½ÃŰ´Â °ÍÀ̶ó°í ´Ü¾ðÇÏ¿´´Ù.
¾×»óºÐÃþÇö»óÀº ¾×ü°¡ ¼·Î ³ª´µ¾îÁö´Â ÈÇÐÀû Çö»óÀ» ÀǹÌÇϴµ¥ ¿Ö ±×·±Áö ¾î¶² ÀÌÀ¯¿¡ ÀÇÇØ¼ ±×·±Áö´Â Àç·áÇÐÀû °üÁ¡¿¡¼ °íÂûÇØ¾ß¸¸ ¸íÈ®ÇÒ °ÍÀÌ´Ù. ·ç »þ¿ÀÃß¾ÓÀº ¾Õ¼ ¸»ÇÑ ¿©·¯ °¡Áö õ¸ñÀ¯ µîÀ» Àü¹®ÀûÀ¸·Î ºÐ¼®ÇÑ ÈÄ Àڱ⸸ÀÇ À¯¾àÀ» âÁ¶ÇÑ °ÍÀ̾ú´Ù. ±×ÀÇ °úÇÐÀû ޱ¸¿¡ ´ëÇÑ ³»¿ëÀ» ÀϺΠÀοëÇÑ´Ù.
"¿ä¿ì¶ì, ÅõÇÏ¿À, µûÀ̸¶¿À µîÀÇ À¯¾àÀº Áß±¹ ÀüÅë»öÀ¯ °¡¿îµ¥ Ư¼öÇÑ ±¸Á¶¸¦ °¡Áø °ÍÀ¸·Î½á °áÁ¤À¯ÀÇ È¿°úµµ ÀÖÀ¸³ª °áÁ¤À¯´Â ¾Æ´Ï´Ù. ±×°ÍµéÀº À¯Á¤Ã¼¿Í ÆÄ¸®Ã¼ÀÇ ¾çÀÚ°¡ È¥¿ëµÇ¾î ÀÖ°í ÆÄ¸®Ã¼ ³»ºÎÀÇ °¢Á¾ ¼ººÐÀÇ Á¶ÇÕÀÌ °í¸£Áö ¾ÊÀ¸¸ç ºñÁß°ú Ç¥¸éÀå·ÂÀÌ °°Áö ¾Ê¾Æ ¾×»óºÐÃþÇö»óÀÌ ÀϾÙ. À̿Ͱ°Àº ¾×»óºÐÃþÇö»óÀº ÀÏÂïÀÌ ¼Û´ëÀÇ Ãá(з)¿ä¿¡¼µµ ³ªÅ¸³µÀ¸¸ç õûÀ¯¿Í º¸¶ó»ö ¹ÝÁ¡(í¹ûõÚèÎÔ) °¡¿îµ¥¿¡µµ ö°ú µ¿ÀÇ ÀÛÀº ¾×Àû(äûîÙ)ÀÌ ¸ðµÎ Á¸ÀçÇϰí ÀÖÀ¸¸ç ÀÌ ¾×ÀûÀº ºñÁ¤Ã¼(ÞªïÜô÷)¿¡ ¼ÓÇÑ´Ù. ±Õ¿äÀÇ ÀÚ±âÀ¯¾à¿¡¼ ³ªÅ¸³ª´Â Ǫ¸¥»öÀÇ ºÎµå·¯¿î ±¤ÅÃÀº À̿Ͱ°Àº ¾×ÀûÀÌ ºûÀ» ¹Ý»çÈ¿°ú ¶§¹®ÀÌ´Ù. "(±×¸²2)

±×¸² 2 áäÓÛËï颡°é¥Ü¨ô¸ÙÍ¡±èÏ
ÀÌ·¯ÇÑ °úÇÐÀû ¿¬±¸ Åä´ëÀ§¿¡ ÀÌ·ç¾îÁø ±×ÀÇ Ã¶È«±Ý±ÇÀ¯ÀÇ ¿¬±¸°á°ú´Â 1981³â Áß±¹ ±¹°¡°úÇבּ¸ °¨Á¤À» Åë°úÇÏ¿´°í 1987³â Áß±¹ °úÇбâ¼úÀ§¿øÈ¸ÀÇ Ã¢Á¶¹ß¸í»óÀ» ¼ö¿©ÇÏ¿´´Ù.
±×ÀÇ ¿¬±¸°á°ú¿¡ µû¸£¸é öȫ±Ý±ÇÀ¯ÀÇ ¾×»óºÐÃþÇö»óÀº ¸ðµÎ 3°³ÀÇ ÃþÀ¸·Î ³ª´¶´Ù.
Á¦1ÃþÀº °¡Àå ¹Ù±ù¿¡ ÀÖ´Â ÃþÀ¸·Î öÀÇ ÇÔ·®ÀÌ ¸¹Àº Àû»ö¹ÝÁ¡ÀÌ ³ªÅ¸³ª°í Ç¥¸éÀå·ÂÀÌ Å©´Ù. ºñÁßÀº ³·À¸¸ç Á¡µµ´Â Å©´Ù. ±×·¯³ª ±Ý»ö Å׵θ®¿Í Ȳ»ö¹ÝÁ¡Àº öÀÇ ÇÔ·®ÀÌ ÀûÀº ¹ÝÁ¡À̸ç Ç¥¸éÀå·Â ¿ª½Ã ÀÛ´Ù. ÁÖ·Î Àû»ö ¹ÝÁ¡ ÁÖÀ§¿¡ »êÀçÇÑ´Ù. Á¡µµ´Â ÀÛÀ¸³ª ºñÁßÀº Å©´Ù.
Á¦2ÃþÀº Áß°£ÃþÀ¸·Î ´ë·®ÀÇ ºÓÀº ¹ÝÁ¡°ú Ȳ»ö¹ÝÁ¡ÀÌ ¿ÜÃþ°ú ³»Ãþ(Á¦3Ãþ)¿¡ °ÉÃÄ ÆÛÁ® ÀÖ´Ù.
Á¦3ÃþÀº ³»ÃþÀ¸·Î ÈæÀ¯¿Í Å©±â°¡ °í¸£Áö ¾ÊÀº ÀÛÀº À¯¾àÀÇ ±âÆ÷·Î ÀÌ·ç¾îÁ® ÀÖ´Ù. Áß°£Ãþ°ú ³»ÃþÀº ¶Ñ·ÇÇÑ °æ°è¼±ÀÌ ¾ø´Ù.
öȫ±Ý±ÇÀ¯´Â ÀüÅëÀûÀÎ ¿ä¿ì¶ì, µûÀ̸¶¿À¿Í´Â Á¶±Ý ´Ù¸£¸ç ¼¼ ¹øÀÇ ¾×»óºÐÃþÇö»óÀ» °ÅÄ£´Ù. ù ¹øÂ° ¾×»óºÐÃþÇö»ó¿¡¼ µ¶¸³µÈ ¾×ÀûÀÇ Å©±â º¯È°¡ Å©´Ù. ´õ¿í Áß¿äÇÑ °ÍÀº ÀÌ ¾×ÀûµéÀÌ ¼·Î ´Ù¸¥ ±¤ÇÐÀû ¼ºÁúÀ» ³ªÅ¸³»´Â °ÍÀÌ´Ù. Áï öÀÇ ÇÔ·®ÀÌ ¸¹À¸¸é Àû»ö ¹ÝÁ¡À» ³ªÅ¸³»°í Ç¥¸éÀå·ÂÀÌ Å©¸ç ¿øÇüÀ̳ª ¹Ý¿øÇüÀ¸·Î ³ªÅ¸³ª°í öÀÇ ÇÔ·®ÀÌ ÀûÀ¸¸é Ȳ»ö ¹ÝÁ¡Àε¥ Ç¥¸éÀå·ÂÀº ÀÛ°í Àû»ö ¹ÝÁ¡ ÁÖÀ§¿¡ »êÀçÇÑ´Ù. ÀÌµé ¾×ÀûÀº ¼·Î ¹ÐÁýÇÏ¿© Àû»ö°ú Ȳ»ö ¹ÝÁ¡ÀÇ º¯È¸¦ Å©°Ô ÇÑ´Ù. (±×¸²3)
±×¸² 3
¾×ÀûµéÀÌ ¹ÐÁýµÇ¾î ÀÖ´Â °÷¿¡¼´Â ¹Ðµµ¿Í ÈÇмººÐÀÇ Â÷ÀÌ¿¡ ÀÇÇØ Á¦2Â÷ ¾×»óºÐÃþÇö»óÀÌ ÀϾ¸ç Àû»ö ¹ÝÁ¡ÀÌ ¹ÐÁýµÈ °÷¿¡´Â Àû»ö ¹ÝÁ¡ ÁÖÀ§·Î Ȳ»ö ¾×ÀûÀÌ ³ªÅ¸³ª¸ç À̵é ÀÛÀº Ȳ»ö ¾×ÀûµéÀÌ ´Ù½Ã ¸ð¿© Àû»ö ¹ÝÁ¡À» µÑ·¯½Ñ ±Ý»ö Å׵θ®¸¦ ¸¸µç´Ù. (±×¸²4)
±×·¯³ª À̿Ͱ°Àº Á¾·ùÀÇ Á¦2Â÷ ¾×»óºÐÃþÇö»óÀº ºÎºÐÀûÀ¸·Î ´Ù¸£°Ô ³ªÅ¸³´Ù. Áï ¸î °³ÀÇ °í¸³µÈ ¾×Àû Áß Ã¶ºÐÀÇ ÇÔ·®ÀÌ ºÎÁ·ÇÑ °ÍÀº Á¦3Â÷ ¾×»óºÐÃþÇö»óÀÌ ÀϾÙ. öºÐÇÔ·®ÀÌ ¸¹Àº ÀÛÀº ¾×ÀûÀÌ È²»ö ¹ÝÁ¡ ÁÖÀ§¿¡ ºÐ»êµÇ¾î ÀÖÀ¸¸ç °°Àº »óȲÀÇ È²»ö ¹ÝÁ¡ ¹ÐÁýÁö¿ª ³»¿¡´Â Ȳ»ö¹ÝÁ¡ ÁÖÀ§¿¡ Çü¼ºµÈ Ȳ°¥»öÀÇ ÀÛÀº Å׵θ®¸¦ º¼ ¼ö ÀÖ´Ù. (±×¸²5)

±×¸² 4
±×¸² 5
»ç½Ç ±×¸²À» º¸¸é¼ ÀÌÇØ¸¦ ÇÏ·Á ÇØµµ ±×¸® ½±Áö ¾ÊÀº ³»¿ëÀÌ´Ù. ´õ¿íÀÌ Ã¶È«±Ý±ÇÀ¯´Â ¼Ò¼º¹üÀ§µµ Á¼°í Á¦¾îÇϱ⵵ Èûµé¸ç Á¶±ÝÀÌ¶óµµ ¼Ò¼ºÁ¶°ÇÀÌ ´Ù¸£¸é ¹ÝÁ¡ÀÇ ¹ß»öÀÌ ÀüÇô ´Ù¸£´Ù°í ÇÑ´Ù.(±×¸²6) ±×·³¿¡µµ ·ç »þ¿ÀÃß¾ÓÀÌ Áö±Ý±îÁö ¿¬±¸¸¦ ¸ØÃßÁö ¾Ê´Â °ÍÀº ÈÇпø¼ÒÁÖ±âÇ¥¿¡ ÀÖ´Â ¾î¶² ´Ù¸¥ ¿ø¼Òº¸´Ùµµ öÀÌ °¡Áø dzºÎÇÑ ¿¹¼úÀû È¿°ú¿¡ ´ëÇÑ °ü½ÉÀº ¹°·Ð ±×°ÍÀÌ °¡Áø ¿¹¼úÀû ¸Å·Â ƯÈ÷ µµ¿¹°¡µéÀÇ Ã¢ÀÇ·ÂÀ» ²÷ÀÓ¾øÀÌ ÀÚ±ØÇÒ ¼ö ÀÖ´Â ºÒ°¡»çÀÇÇÑ ¸Å·ÂÀ» ÀÍÈ÷ ¾Ë°í Àֱ⠶§¹®À̶ó°í »ý°¢ÇÑ´Ù.

±×¸² 6
2ȸ¿¡ °ÉÃÄ Áß±¹ÀÇ ¿ø·Îµµ¿¹°¡ µÎ »ç¶÷À» ¼Ò°³ÇÏ°Ô µÈ °ÍÀº ÇÊÀڷμ´Â ¹«Ã´ Çà¿îÀ̾ú´Ù°í »ý°¢ÇÑ´Ù. ºÎºÎ°¡ °°Àº Çб³¿¡ ÀçÁ÷ÇÏ¸é¼ ¼·Î Ãß±¸ÇÏ´Â ¹æÇâÀº ´Ù¸£Áö¸¸ °øÅëÀûÀÎ »ç½ÇÀº À°Ã¼ÀÇ ³ªÀ̸¦ ³ÑÀº Çй®Àû ¿Á¤°ú ³ë·ÂÀ̾ú´Ù. ƯÈ÷ ¯ ¼î¿ìÂê±³¼ö¿Í ·ç »þ¿ÀÃß¾Ó±³¼öÀÇ ÀÚ·á´Â ÇÊÀÚ°¡ Áö±Ý±îÁö ¿Ü±¹ ÀÛ°¡¸¦ ¼Ò°³Çϱâ À§ÇØ ¹ÞÀº ¾î¶² ÀڷẸ´Ù ±¸Ã¼ÀûÀ̾ú°í Àû±ØÀûÀ̾ú´Ù. ÀÚ½ÅÀÇ ÀÛǰÀ» ¼Ò°³ÇÏ´Â °ÍÀº ¹°·ÐÀÌÁö¸¸ ±×°ÍÀÇ Çй®Àû ¹è°æ±îÁö Àϸñ¿ä¿¬ÇÏ°Ô Á¤¸®ÇØÁØ ¹è·Á¿¡ °æÀǸ¦ Ç¥Çϸç, ±×·¯ÇÑ ÀþÀº »ç°í°¡ Çö´ë Áß±¹µµ¿¹ÀÇ °ßÀÎÂ÷°¡ µÇ°í ÀÖÀ½À» »õ»ï ´À³¥ µû¸§ÀÌ´Ù.

öȫ±Ý±ÇÀ¯ÀÛǰ¡°ô¸Í®û¾¡±1994³â, ³ôÀÌ 350mm

öȫ±Ý±ÇÀ¯ÀÛǰ¡°Í®ãýܺ¡±1994³â, ³ôÀÌ 155mm

öȫ±Ý±ÇÀ¯ÀÛǰ¡°ÐÝü»èÏ¡±1981³â, Áö¸§ 125mm

öȫ±Ý±ÇÀ¯ÀÛǰ¡°ÛåàøÜº¡±1994³â, ³ôÀÌ 300mm
------------------------------------------
< ÁÖ ¼® >
1) ÀϺ»¾î·Î´Â ¿ä¿ìÇîµ§¸ðÄí¶ó°í ÇÏÁö¸¸ À̱ۿ¡¼´Â Áß±¹¾î½Ä Ç¥±â¸¦ µû¸¥´Ù.
2) Glass former, À¯¸® ¶Ç´Â ¼öÁ¤À» ÀǹÌÇϸç À¯¸®ÁúÈµÈ À¯¾àÀ» °¡¸®Å²´Ù.
3) Oil spot Glaze, ±â¸§¹æ¿ïÀ» ¶³¾î¶ß¸° µíÇÑ ÀÛÀº ¹ÝÁ¡ÀÌ ÀÖ´Â À¯¾à
4) Hare's fur glaze, ¸» ±×´ë·Î Åä³¢Åаú ÀÛÀº °¡´Ã°í ±ä ¹ÝÁ¡ÀÌ ÀÖ´Â À¯¾à
5) Tortoise shell markings glaze, ÈæÀ¯À§¿¡ Ȳ¹é»öÀÇ ½ÇÅõÀ¯¸¦ °ãÃÄ ¹ß¶ó ¼Ò¼ºÇÏ¸é ³ªÅ¸³ª´Â ºÒ±ÔÄ¢ÇÑ ¹ÝÁ¡ÀÌ ¹Ù´Ù°ÅºÏÀÇ µî²®Áú »ö, Áú°¨°ú °°´Ù°í ÇÏ¿© ºÙÀº À̸§.
6) Red oil spot, À¯ÀûÀ¯¿Í À¯»çÇϳª ¹ÝÁ¡ÀÇ »öÀÌ ºÓÀº»öÀ» ¶í´Ù.